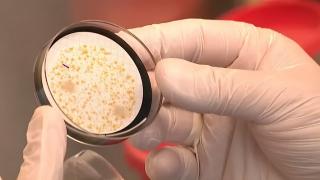

- 14:35 Kahramanmaraş'ta okulda silahlı saldırı
- 18:59 Sürücüler Dikkat: Vorarlberg’de Bu Akşam Zor Hava Koşulları
- 19:05 Pfändertunnel’de Zincirleme Kaza: Dört Araç Çarpıştı, Trafik Kilitlendi
- 18:44 İGGÖ’den hükümete açık mektup: Siyasi dil, Müslümanlarda dışlanmışlık duygusunu artırıyor
- 14:16 Kitlesel balık ölümü araştırılıyor
- 12:50 İslamofobi Artık Açıkça Yapılıyor: ÖVP’nin Paylaşımı Tepki Topladı
- 21:32 Ferdi ve Gülcan Nurten Avusturya’nın Kahramanları Arasında
- 09:07 ATİB Lustenau’da Tarihi Dayanışma: Bağışlar 1,9 Milyon Euroyu Aştı
- 17:44 Geniş kapsamlı arama Vorarlberg trafiğini zorluyor: Sebebi hâlâ belirsiz
- 13:25 Lochau’da Türk işletmesine ikinci soygun